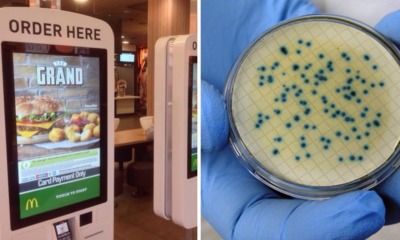
Touchscreen Menus at McDonald's UK Are So Gross, Tests Found Traces of Human Faeces on Them - WORLD OF BUZZ

If you’re always hanging out or running errands near Jalan Telawi in Bangsar, please be careful because someone else just fell victim to a snatch theft...


This is definitely something you DON’T want to see in your food! This mother in Beijing got the shock of her life when the chicken wings...


If you are anything like us, surely there are rare seasonal items on the Mcdonald’s menu that you will definitely order and makan. Apparently, in Singapore, there...


A mother’s love is priceless and there’s no doubt that this woman would do anything to see her family happy. Just recently, news of a Filipino...


Here at World of Buzz, we loooove our Chicken McNuggets, so you can imagine our excitement when we found out that McDonald’s has released not only...


THIS JUST IN GUYS! A brand new item just got introduced on McD’s menu and a lot Malaysians are already raving about it! We are super excited...


Sometimes, it’s not about how much a romantic date costs, it’s about the effort behind it! Though some may look down upon the idea of celebrating Valentine’s...


Some of us like onions in our burgers and some of us don’t. But some people hate them so much, they will call the police if...


As the season of love is approaching fast, there’s only one thing on everyone’s mind, “What should I buy for my boyfriend/girlfriend this Valentine’s Day?” We...


Following the events of the 14th general election, the Pakatan Harapan (PH) government reintroduced the Sales and Services Tax (SST) in September 2018 after zero-rating the...


Customers may always be right, but that’s no reason to hurt someone. Around a month ago, a clip went viral showing a customer throwing food at...

A recent investigation carried out by journalists from Metro UK found some rather disturbing evidence after samples were taken from new touchscreen menu machines located in eight...


Be careful if you frequent Cheras near this mall! According to a Facebook post, on Thursday (27 Sept), a man pretended to be an Indonesian police...


We’ve all enjoyed a good burger at McDonald’s every now and then, but have any of us ever thought of redecorating the place? Well, these guys...


Anyone remember the Great Nasi Lemak War of 2017, when Malaysians and Singaporeans were arguing after McDonald’s Singapore came out with a nasi lemak burger for...


If we’re honest, most durian buffets are usually over-hyped and often end up disappointing customers. However, we have a feeling that this one is going to...